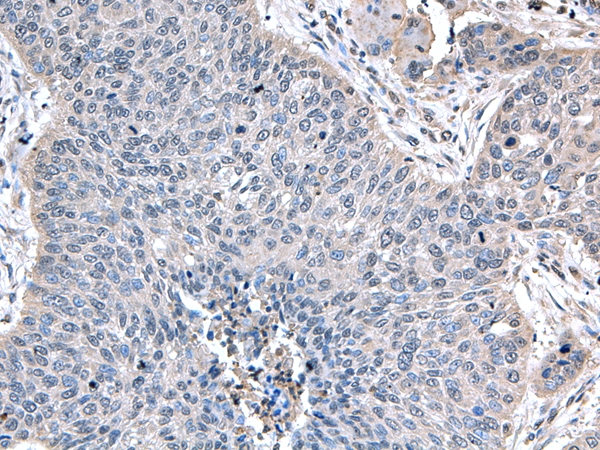
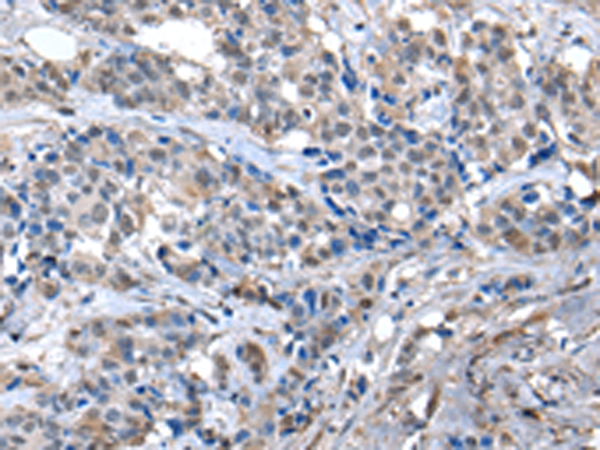
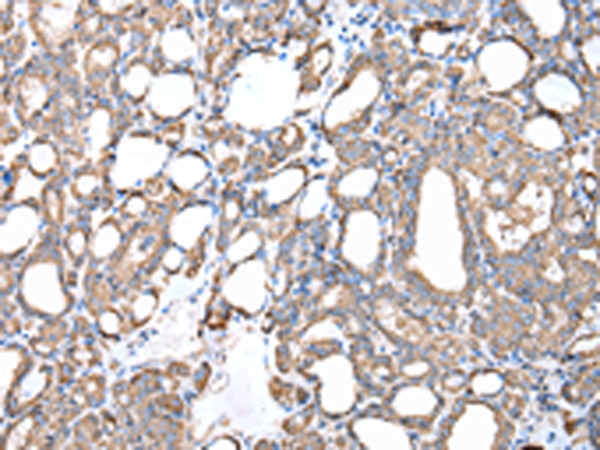
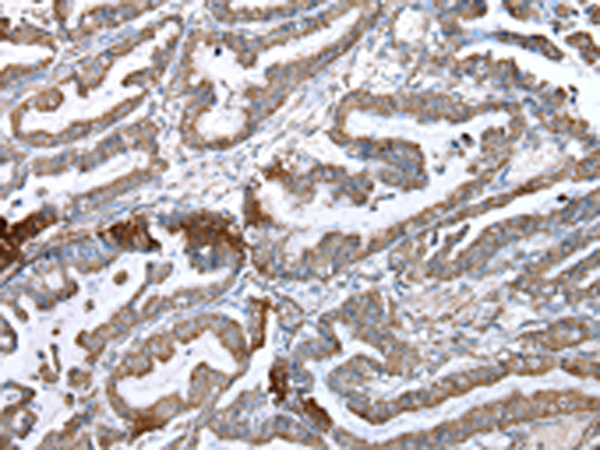
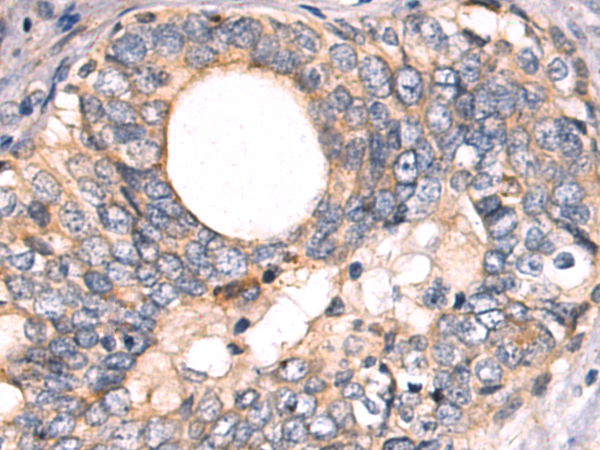

-
分类: 科研抗体货号: P09015别名: ZA20D2; ZNF216; ZFAND5A应用: WB,IHC反应种属: Human, Mouse, Rat
-
分类: 科研抗体货号: P09002别名: PPD; LIBC; PPAC; WISP3; WISP-3应用: WB,IHC反应种属: Human, Mouse
-
分类: 科研抗体货号: P09021别名: KOX16; ZNF359; ZNF612; Zfp612应用: IHC反应种属: Human
-
分类: 科研抗体货号: P09013别名:应用: WB,IHC反应种属: Human, Mouse
-
分类: 科研抗体货号: P09001别名: WIF-1应用: WB,IHC反应种属: Human, Mouse, Rat
-
分类: 科研抗体货号: P09019别名: ZNF751应用: IHC反应种属: Human, Mouse
-
分类: 科研抗体货号: P09012别名: DHHC-20; 4933421L13Rik应用: IHC反应种属: Human, Mouse
-
分类: 科研抗体货号: P09031别名: RPB12; RPABC4; RPB7.0; hRPB7.0; hsRPB10a; RPB10alpha; ABC10-alpha应用: IHC反应种属: Human, Mouse
-
分类: 科研抗体货号: P09018别名: PZF; DMS-8; DSM-8; FKSG11; ZFP-91; ZNF757应用: IHC反应种属: Human, Mouse
-
分类: 科研抗体货号: P09045别名: QCR6; UQCR8应用: WB,IHC反应种属: Human, Mouse, Rat

鄂公网安备42018502007531号
鄂公网安备42018502007531号

